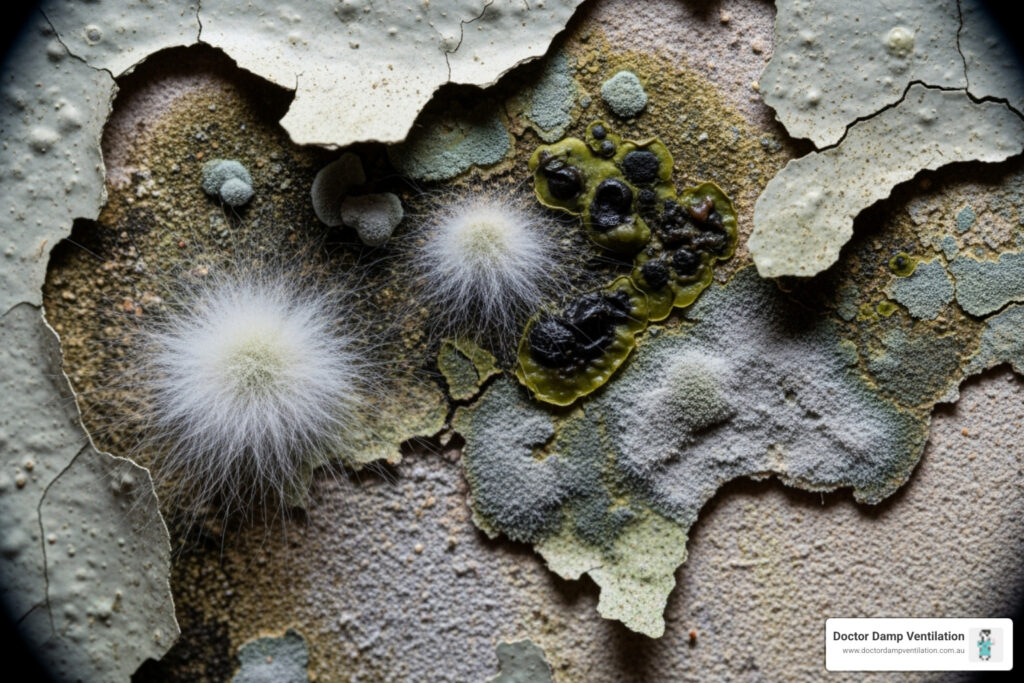
mould fumigation

Get the true rising damp definition. Learn causes, signs, and effective treatment for your Sydney home. Protect your property now!
Category Archives: Sub Floor ventilation
Uncover the hidden cost of mould in your Sydney home. Explore remediation, health risks, and prevention strategies for a healthy future.
Say goodbye to black mould removal Sydney! Protect your home & health. Get expert tips, DIY advice, and professional solutions.
Stop rising damp! Learn how to fix rising damp in your Sydney home. Get expert tips on diagnosis, causes, treatments, and prevention.
Considering mould fumigation? Uncover its effectiveness, health risks, and why comprehensive mould removal is the true solution.
Protect your Strathfield home & health from mould. Discover expert mould removal Strathfield services, addressing causes & providing long-term solutions.
Banish black mould in bathroom! Learn to identify, safely remove, and prevent it for a healthier home.
Worried about dampness in wall? Learn to identify, treat, & prevent rising, penetrating, and condensation.
Stop mould in its tracks! Get expert mould remediation Sydney services for a healthy home. Learn signs, risks & prevention.
Protect your Gold Coast home & health! Learn mould signs & why expert home mould inspection Gold Coast is vital for prevention.